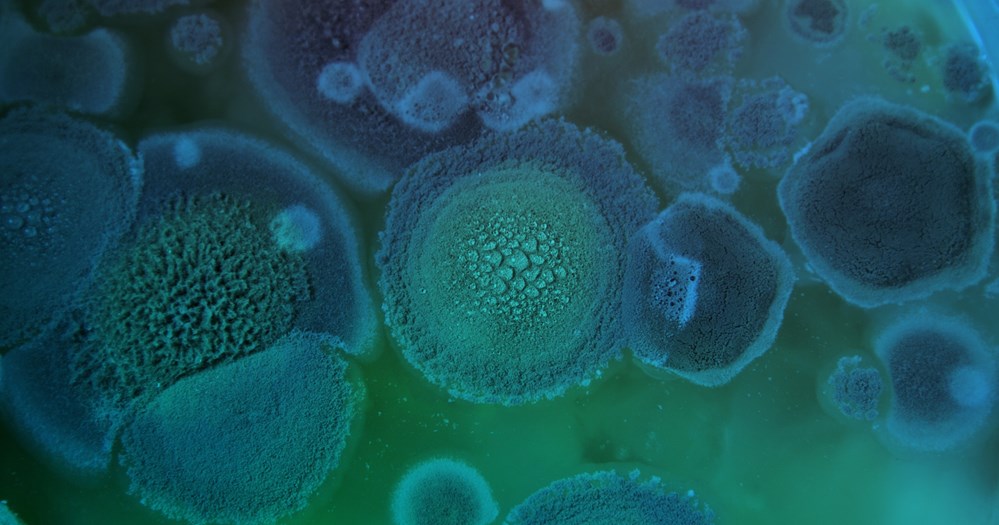

Meet the Team
Savillex, ONFAB, and Optimum Processing family of brands

Eric Giesing, CEO
Eric Giesing became Chief Executive Officer of Savillex in November 2024, leading the company’s strategic vision with a focus on scaling operations, strengthening innovation pipelines, and advancing the ONFAB, Savillex, and Optimum Processing brands. His expertise in business development, product management, strategy, and commercial execution continues to drive the company’s growth. Before joining Savillex, Eric served as Chief Commercial Officer at Fortis Life Sciences and held multiple leadership roles at Danaher Corporation, where he contributed to significant commercial and product development achievements across global markets. Eric holds bachelor’s and master’s degrees in science from the University of Illinois Urbana-Champaign. Beyond his professional work, Eric is a proud girl dad who brings the same intention and dedication to his family life as he does to leading his team. He enjoys traveling, hiking, camping, and making the most of time spent with loved ones. He values meaningful experiences both personally and professionally everywhere.

Steve Harding, CFO
Steve Harding serves as Chief Financial Officer of Savillex, overseeing all aspects of financial management while guiding day-to-day operations across the organization. His deep understanding of the company, strengthened by his years with Savillex beginning in 2013 and later with ONFAB in 2025, makes him an essential leader within the Savillex and ONFAB family of brands. Before his current role, Steve held executive and director level positions in the medical device and automotive industries, bringing nearly 30 years of financial management experience to the organization. His broad operational and financial expertise supports the company’s long-term growth and stability. Steve is an alumnus of the University of Minnesota Carlson School of Management, where he earned a bachelor’s degree in accounting. Outside of work, Steve values time with family and enjoys staying active, bass fishing with his wife, and engaging in activities that keep him learning and connected.

Jocelyn Foye, Head of Sales
As Head of Sales at Savillex, Jocelyn Foye leads global commercial strategy, revenue growth initiatives, and customer engagement across the organization’s life sciences portfolio. With more than 22 years of experience in the life sciences industry, she brings a strong track record of building high-performing teams, developing strategic partnerships, and scaling commercial operations to drive sustained growth. Prior to joining Savillex, Jocelyn held senior leadership roles at Corning Life Sciences, Fortis Life Sciences, and Sartorius, where she consistently delivered strong financial performance and expanded market presence across complex product portfolios. She has successfully launched new business units, led global partnership initiatives, and developed go-to-market strategies for innovative technologies, including next-generation antibody solutions. Jocelyn is known for her data-driven and customer-centric approach to sales leadership, leveraging advanced analytics to inform strategy, optimize performance, and deepen key account relationships. Throughout her career, she has collaborated closely with executive leadership to align commercial objectives with broader organizational goals, driving operational excellence, and long-term value creation. She holds a Bachelor of Science in Biology from the University of Vermont and brings a deep technical foundation to her leadership in the life sciences sector. Jocelyn enjoys spending time with her family outside playing sports, going to the beach in the summer, and skiing in the winter.

Nathan Wakefield, General Manager - ONFAB and OPI
Nathan Wakefield serves as General Manager of ONFAB and Optimum Processing, bringing over a decade of operational leadership experience to the organization. He is committed to building high trust, high-performing team cultures, and leads by example, fostering collaboration and continuous improvement across all levels. Nathan focuses on streamlining processes, strengthening operations, and supporting teams through a customer-first mindset. He also leads the expansion of manufacturing capabilities across the UK, Europe, and the US to support a global customer base. Before his current role, Nathan began his journey at Optimum Processing, where he designed and implemented an ISO 9001 certified Quality Management System from the ground up, laying out the foundation for the company’s growth. Nathan earned his bachelor’s degree in project management from California State University, Chico.

Kaitlynn Bakk, Head of Quality
Kaitlynn Bakk serves as Head of Quality at Savillex, where she leads the Global Quality Team and oversees internal audits, product quality inspection, root-cause analysis, and the implementation and continuous improvement of quality systems and processes. Since joining Savillex in 2023, she has played an integral role in strengthening compliance and driving operational excellence across the organization. Before assuming her current role, Kaitlynn built nearly five years of quality assurance experience and three years of life science laboratory experience, including authorship on two peer reviewed journal articles. She is formally trained as an ISO 13485:2016 Lead Auditor with additional specialization in risk management. Kaitlynn earned her bachelor’s degree in biology from Augustana University. Outside her professional work, she enjoys hiking, rock climbing, disc golfing, and crafting—and is an avid traveler who counts the Sequoia National Park among her favorite destinations.

John Beauchamp, Director of Operations
John Beauchamp joined Savillex in 2022 and was promoted to Director of Operations in October 2025. In this role, he oversees operations and manufacturing, ensuring high-quality fluoropolymer components and custom assemblies for life sciences, aerospace, semiconductor, and analytical testing markets. John previously led the Savillex quality team for three years, where he implemented an ISO 9001 compliant Quality Management System and strengthened core quality processes across the organization. Prior to joining Savillex, he spent 29 years at R&D Systems, Inc., a Bio-Techne brand, serving in roles that included leadership of quality, product support, and process improvement teams. His extensive background in regulated manufacturing environments continues to inform his operational- and quality-driven approach. John holds a degree from the University of Minnesota College of Biological Sciences, where he also spent two years as a scientific staff member. Outside of work, John enjoys numerous outdoor activities, DIY home projects, and auto mechanics.

Jennifer Placek, Director of Product Management
Jennifer Placek serves as Director of Product Management at Savillex, leading strategy and development for the company’s single-use bioprocessing portfolio. Jennifer is recognized for her strong technical foundation, customer centric mindset, and ability to translate complex requirements into scalable, high-performance products. Based in California, she partners closely with cross-functional teams to support reliable solutions for the life sciences industry. Jennifer has extensive experience in bioprocess consumables and product leadership, most recently serving as a product manager at Cytiva, where she advanced innovative solutions aligned with customer and manufacturing needs. Before joining Cytiva, she held roles across the life sciences sector, further strengthening her expertise in product development and commercialization. Jennifer earned her Master of Science degree from San Francisco State University. Beyond her professional work, Jennifer enjoys creating pottery, hiking with her dogs, traveling the world, discovering experiences, exploring pursuits, and spending time in nature.

David McKeown, Director of IBM Operations
David McKeown serves as Director of IBM Operations at Savillex, where he oversees PETG manufacturing operations. He brings extensive experience in fluoropolymer manufacturing, ensuring the consistent delivery of high-quality products across the life sciences, aerospace, semiconductor, and analytical testing markets. David offers deep institutional knowledge, having spent more than 18 years in operations, manufacturing, and quality leadership roles within the organization. His leadership style is characterized by calm confidence, clear expectations, and a genuine desire to see others succeed. Before joining Savillex, David held quality leadership roles with ATMI (later Entegris), where he managed ISO 9001 and ISO 14001 systems. He later served as Director of Quality at Mendell, building a strong foundation in quality systems, lean manufacturing, and continuous improvement. David earned his degrees from Northland International University and Tri-State Baptist College. Outside of work, he is a devoted family man and builder by nature—whether that means building teams, crafting furniture, or investing in people.

Carrie Halle, Director of Marketing
Carrie Halle serves as Director of Marketing at Savillex, where she leads marketing strategy, demand generation, and brand development to support the company’s expanding portfolio of high-performance containers and containment solutions. In this role, she partners closely with sales, product, and leadership to strengthen market presence, accelerate growth in regulated industries, and drive Voice of the Customer across the organization. Before joining Savillex, Carrie held senior global marketing leadership roles at Danaher, where she delivered significant pipeline growth, led major product launches, advanced digital marketing strategy, and managed high-performing teams across multiple business units. With more than 20 years of experience in life sciences, biotechnology, and advanced manufacturing, she is recognized for her customer-centric approach and ability to translate insights into measurable commercial impact. Carrie holds both an MBA and BBA in marketing from the University of Wisconsin–Madison. Beyond her professional work, she enjoys cycling, hiking, skiing, and spending quality time with family and friends.
